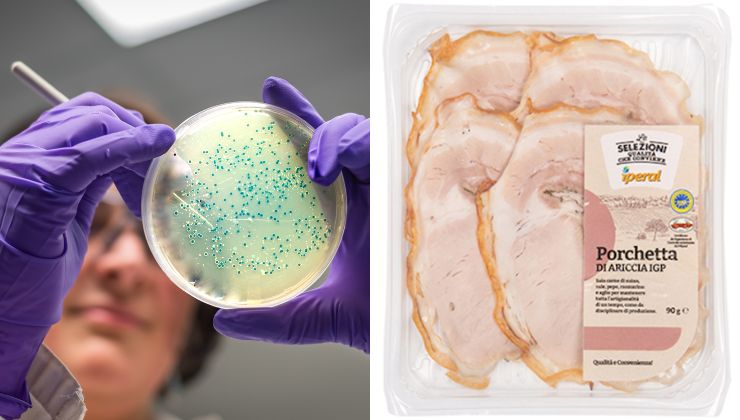

Nuova allerta alimentare in tutti i supermercati, per questo prodotto ottimo che si trova dentro la dispensa.

È allerta alimentare per un prodotto in cui sono stati trovati dei batteri potenzialmente pericolosi per l’uomo. Il prodotto, sempre presente in dispensa, non dovrà essere consumato come da richiesta specifica del Ministero della Salute tramite il suo richiamo presente sul sito ufficiale. Non sono pochi i prodotti che in questo periodo sono stati ritirati per sicurezza e che potrebbero contentere il batterio Listeria monocytogenes. Facciamo chiarezza sul tipo di prodotto e che cosa ha specificato il Ministero della Salute in queste ultime ore.
Listeria cosa è e sintomi
Prima di capire quale sia il prodotto che il Ministero della salute ha ritirato, ricordiamo che i controlli che vengono svolti sono importanti per la salute dei consumatori. Ci possono essere motivazioni differenti a seguito di un controllo, nella maggior parte dei casi con segnalazione di potenziale pericolo o comunque necessità.

Tante volte alcuni prodotti sono stati ritirati perché manca una dicitura in etichetta, ci sono degli allergeni non segnalati o delle potenziali contaminazioni che è il caso di verificare a fondo. Insomma, tutto deve essere sempre al massimo della sicurezza per i consumatori finali.
A tal proposito, l’ultimo ritiro da parte del Ministero della Salute è stato deciso proprio perché ci potrebbe essere un’allerta di batteri e più precisamente il Listeria monocytogenes.
Quest’ultimo si trova all’interno del terreno e dentro l’acqua, per questo motivo è in grado di contaminare verdure – latte – alimenti confezionati e formaggi. I soggetti che ingeriscono un prodotto contaminato, potranno avere alcuni sintomi similari a quelli dell’influenza che si risolvono al massimo in una settimana.
Ovviamente, i sintomi cambiano a seconda del soggetto e al tipo di infezione da valutare sempre con un professionista esperto del settore.
Prodotto ritirato al supermercato: lotto e caratteristiche
Il Ministero della Salute ha predisposto il richiamo di un prodotto che è potenzialmente pericoloso. Stiamo parlando della Porchetta di Ariccia a marchio IGP della Selezioni Alta Qualità Iperial.
Questo provvedimento è stato deciso a seguito della possibile presenza di Listeria Monovytogenes. Nel dettaglio sono segnalate le confezioni di 90 grammi di prodotto con i seguenti lotti:
- V236049
- V232703
- V232134
- V235970
- V233395
- V234224
- V234230
La data di scadenza è al 31/10/2022. Questa tipologia di Porchetta è di produzione per i Supermercati Iperial SpA in nome del Prosciuttificio San Michele srl di Lesignano de’ Bagni – Parma. Il suo marchio identificativo è CE IT 1019L.
Nei giorni precedenti era già stata segnalata una confezione di porchetta dello stesso marchio, con lotto V233557 scaduta al 14/10/2022 con motivazione generica e non specifica come in questo caso.
Chi possiede una confezione di questa Porchetta con lotto e scadenza come sopra riportato è invitato a riportarla al supermercato. Dopo un controllo da parte dello staff, la confezione verrà ritirata e ci sarà un rimborso della somma spesa. In ogni caso, il Ministero della Salute vieta il consumo delle confezioni con lotti e scadenza menzionati sopra e nel richiamo.







